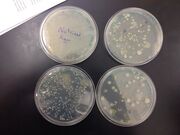
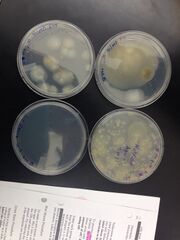

Uploads by Jenna Wiegand
From OpenWetWare
Jump to navigationJump to search
This special page shows all uploaded files.
| Date | Name | Thumbnail | Size | Description |
|---|---|---|---|---|
| 01:57, 23 March 2016 | Screen Shot 2016-03-22 at 6.59.08 PM.png (file) |  |
122 KB | 14 pdf |
| 01:56, 23 March 2016 | Screen Shot 2016-03-22 at 6.58.59 PM.png (file) |  |
118 KB | 7 pdf |
| 01:54, 23 March 2016 | Screen Shot 2016-03-22 at 6.58.44 PM.png (file) |  |
122 KB | averages for 5pdf |
| 01:51, 23 March 2016 | Screen Shot 2016-03-22 at 9.49.29 PM.png (file) |  |
271 KB | This is a photo of the diagram of our ZF experiment the treated group |
| 01:50, 23 March 2016 | Screen Shot 2016-03-22 at 9.49.19 PM.png (file) |  |
248 KB | This is a photo of the diagram of our ZF experiment the control group |
| 02:47, 14 March 2016 | IMG 1512.JPG (file) |  |
1.39 MB | Photo of Food web |
| 17:02, 17 February 2016 | IMG 1474.JPG (file) |  |
1.29 MB | Table of invertebrates |
| 21:45, 10 February 2016 | IMG 1446.JPG (file) |  |
1.14 MB | |
| 21:38, 10 February 2016 | IMG 8240.jpeg (file) |  |
1.15 MB | Table 1 part 2 |
| 21:37, 10 February 2016 | IMG 5389.jpeg (file) |  |
1.54 MB | Table 1 part 1 |
| 21:27, 3 February 2016 | IMG 2342.JPG (file) | |
1.66 MB | Plates without tetracycline |
| 21:26, 3 February 2016 | IMG 2341.JPG (file) | |
1.8 MB | Photo of plates with Tet+ |
| 21:22, 3 February 2016 | IMG 1367.JPG (file) |  |
2.02 MB | 100-fold serial dilutions results |
| 21:11, 3 February 2016 | IMG 1366.JPG (file) |  |
1.69 MB | Serial dilution diagram |
| 21:06, 3 February 2016 | Haybottom.jpg (file) |  |
965 KB | |
| 22:30, 27 January 2016 | IMG 1232.JPG (file) |  |
1.64 MB | Side view of Hay Infusion |
| 19:34, 27 January 2016 | IMG 2302.JPG (file) |  |
3.61 MB | Photo of transect |
| 19:33, 27 January 2016 | IMG 2305.JPG (file) |  |
3.06 MB | Photo of transect |
| 19:32, 27 January 2016 | IMG 2314.JPG (file) |  |
2.48 MB | Photo of transect |
| 19:31, 27 January 2016 | IMG 2309.JPG (file) |  |
2.94 MB | Photo of transect |
| 19:31, 27 January 2016 | IMG 2299.JPG (file) |  |
3.1 MB | Photo of transect |
| 19:30, 27 January 2016 | IMG 2300.JPG (file) |  |
3 MB | Photo of transect |
| 19:29, 27 January 2016 | IMG 2301.JPG (file) |  |
3.17 MB | Photo of Transect |
| 00:14, 21 January 2016 | IMG 2040.JPG (file) |  |
1.24 MB | Photo of Peranema |
| 22:53, 20 January 2016 | IMG 2275.JPG (file) |  |
2.13 MB | Hand drawn transect description |
| 21:02, 20 January 2016 | Screen Shot 2016-01-20 at 2.29.18 PM.png (file) |  |
509 KB | Aerial View of Transect 1/20/16 |